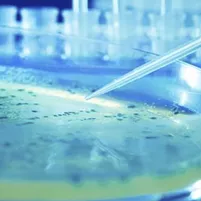

Antimicrobial resistance

Antimicrobials, such as antibiotics, are substances used to kill microorganisms or to stop them from growing and multiplying. They are commonly used in human and veterinary medicine to treat a wide variety of infectious diseases.
Antimicrobial resistanceThe ability of microorganisms (such as bacteria, viruses, fungi) to survive exposure to antimicrobials. This phenomenon, driven largely by the overuse and misuse of antimicrobial agents (e.g. antibiotics, fungicides used as plant protection agents, etc), makes infections harder to treat and poses a significant threat to public health. (AMR) refers to the ability of microorganisms to withstand antimicrobialSubstance used to kill microorganisms or inhibit their growth/multiplication. Antimicrobials such as antibiotics are commonly used in human and veterinary medicine to treat a wide variety of infectious diseases treatments. The overuse or misuse of antibiotics has been linked to the emergence and spread of microorganisms which are resistant to them, rendering treatment ineffective and posing a serious risk to public health. A well known example of a bacterium that has acquired resistance to multiple antibiotics is Meticillin-resistant Staphylococcus aureus (MRSA).
Resistant bacteria can spread through many routes. When AMRAbbreviation of “antimicrobial resistance” (see “antimicrobial resistance”). occurs in zoonotic bacteria present in animals and food it can also compromise the effective treatment of infectious diseases in humans.
In the field of food safety, policy makers need to protect consumers from risks related to the food chain and to establish the best control options to reduce such risks. Scientists and risk assessors are examining the factors which may lead to the presence of antimicrobial resistant bacteria in food and animals to provide appropriate scientific advice to decision makers.
Latest
EFSA and ECDC publish the joint annual scientific report “The European Union summary report on antimicrobial resistance in zoonotic and indicator bacteria from humans, animals and food in 2022–2023”
It reveals that resistance to commonly used antimicrobials — such as ampicillin, tetracyclines, and sulfonamides— remains persistently high in both humans and animals for key pathogens including Salmonella and Campylobacter. Resistance in E. coli is also frequently observed in animals, although resistance of Salmonella in laying hens is low.
EFSA also published several interactive communication tools:
Ongoing and completed assessments
Follow EFSA's work
Explore the data through our data visualisation tool “Antimicrobial resistance in Europe”.
Milestones
2025
April
EFSA updates its scientific opinion on carbapenemase-producing Enterobacterales (CPE) in the food chain, identifying key findings, data gaps and recommendations to strengthen monitoring and control efforts across the EU/EFTA.
January
EFSA, ECDC, ECHA, EEA and EMA, supported by the JRC, publish a joint inter-agency report on the impact of the use of azole fungicides, other than as human medicines, on the development of azole-resistant Aspergillus spp. Under the One Healthintegrated, unifying approach that aims to sustainably balance and optimise the health of people, animals and ecosystems approach, EU experts from human and veterinary medicine, agriculture and environmental sciences review existing evidence, identify factors that promote azole resistance, and propose measures to prevent and control it.
2024
July
EFSA publishes technical specifications for an EU-wide baseline survey on antimicrobial resistance (AMR) in bacteria from aquaculture animals. The document includes guidelines on target populations, the sample size for the survey, sample collection requirements, the analytical methods and the data reporting requirements.
February
EFSA, EMA and ECDC publish their fourth joint inter‐agency report on integrated analysis of data on antibiotic consumption and development of antimicrobial resistance in Europe (2019-2021). Countries that have decreased their consumption of antibiotics in both animals and humans have seen a reduction in antibiotic-resistant bacteria.
January
EFSA publishes an EFSA-funded research project report on the use of antibiotics in plant protection. The report highlights data gaps, resistance hotspots, and alternative measures to control phytopathogenic bacteria.
2022
October
EFSA publishes a scientific opinion assessing the risk of spread of antimicrobial resistance among poultry, pigs and cattle during transport between farms or to slaughterhouses. The opinion outlines the main risk factors, mitigation measures, and data gaps.
March
OECD, ECDC, EFSA and EMA present the briefing note “Antimicrobial Resistance in the EU/EAA – One Health Response” (PDF) to the French presidency of the EU council. It includes data on consumption of antibiotics in humans and food-producing animals, policy options and highlights the importance of cooperation across disciplines, sectors and countries.
2021
October
Experts assess the concentrations of antimicrobials resulting from cross-contamination in feed for food-producing animals that do not lead to the development of resistant bacteria. They also assess the levels of antimicrobials that have a growth promotion or yield increase effect. One scientific opinionOpinions include risk assessments on general scientific issues, evaluations of an application for the authorisation of a product, substance or claim, or an evaluation of a risk assessment describes in detail the methodology used and provides general conclusions and recommendations, and 12 opinions report the result of the assessment performed for 24 substances. A public consultation was carried out on the methodology used for the assessment.
June
EFSA, EMA and ECDC publish their third joint inter‐agency report on integrated analysis of data on antibiotic consumption and development of antimicrobial resistance in Europe (2016-2018). Experts conclude that use of antibiotics has decreased and is now lower in food-producing animals than in humans.
EFSA experts assess the role of food producing environments in the emergence and spread of AMR. They identify the main sources of AMR bacteria and genes, although current data do not allow quantification of the specific contribution each of them makes to this global problem.
2017
October
EFSA, the European Medicines Agency (EMA) and the European Centre for Disease Prevention and Control (ECDC) establish a set of indicators to help EU Member States assess their progress in reducing the use of antimicrobials.
January
Experts from EFSA and EMA review measures taken in the EU to reduce use of antimicrobials in animals and stress that there is no one-size-fits-all solution. Successful strategies follow an integrated, multifaceted approach which takes into account the local livestock production system and involves all relevant stakeholders.
Since 2011
EFSA and ECDC have been compiling a joint report on AMR in zoonotic bacteriabacteria present in animals and food that can cause human infections affecting humans, animals and food. This annual report makes an important contribution to work being carried out at European level and supports the European Commission as it develops proposals to fight AMR.
2009
November
EFSA, ECDC, EMA and the European Commission’s Scientific Committee on Emerging and Newly Identified Health Risks (SCENIHR) publish a joint scientific opinion on AMR focused on infections that can be transmitted to humans from animals and food (i.e. zoonotic diseases).
March
EFSA assesses the public health significance of meticillin-resistant Staphylococcus aureus (MRSA) in animals and foods. It concludes that livestock-associated MRSA represents only a small proportion of all reported MRSA infections in the EU with significant differences between Member States.
2008
April
EFSA experts examine how food may become a vehicle for transmitting resistant bacteria to humans and make recommendations for preventing and controlling transmission. EFSA publishes further specifications for the harmonised monitoring of AMR in Escherichia coli and enterococci bacteria in animals and foods.
2007
EFSA publishes specifications for the harmonised monitoring of antimicrobial resistance in two important zoonotic bacteria – Salmonella and Campylobacter – found in animals and foods.
EFSA's role
EFSA provides independent scientific support and advice to risk managers on the risks to human and animal health related to the possible emergence, spread and transfer of AMR in the food chain and in animals. EFSA takes an integrated approach to its work on antimicrobial resistance involving a number of its Scientific Panels and Units as it is a concern for the entire food chain.
In its work, EFSA cooperates closely with other relevant EU agencies such as the European Centre for Disease Prevention and Control (ECDC) and the European Medicines Agency (EMA).
Monitoring and analysis of antimicrobial resistance in the food chain
EFSA monitors and analyses the situation on AMR in food and animals across Europe. The Authority is assisted by the Network for zoonoses monitoring data, a pan-European network of national representatives and international organisations that assist EFSA by gathering and sharing information on zoonoticA term given to diseases and infections that can be transmitted between animals and humans diseases in their respective countries.
Based on data collected by the EU Member States, EFSA produces in cooperation with ECDC annual European Union Summary Reports on zoonotic infections, food-borne outbreaks and AMR illustrating the evolving situation in Europe. EFSA also publishes baseline survey reports on the prevalenceThe proportion of a population found to have a condition of antimicrobial resistance in the EU in specific animal populations, for instance MRSA in pigs, and provides guidance to national authorities how to carry out their monitoring and reporting activities.
EFSA’s Scientific Panels review the annual reports and make recommendations on prevention and reduction measures.
Risk assessments and recommendations
EFSA’s Scientific Panels assess the risks of antimicrobial resistance and provides scientific advice on control options at the request of risk managers or on its own initiative. This work has included risk assessments by the Panel on Biological Hazards on antimicrobial resistance in the food and feed chain and the public health significance of MRSA in animals and food focusing on the specific type of MRSA found in food-producing animals. The Panel on additives and products or substances used in animal feed assesses the safety of animal feed additives, including the risks related to antibiotic resistance where micro-organisms are involved.
EU framework
To tackle antimicrobial resistance, a holistic, multi-sectorial approach, involving many different sectors (human medicine, veterinary medicine, research, animal husbandry, agriculture, environment, trade and communication) is needed.
In June 2017 the Commission adopted the EU One Health Action Plan against AMR, as requested by the Member States in the Council conclusions of 17 June 2016. It builds on the 2011 action plan, its evaluation, the feedback received on a European Commission Roadmap on AMR and a public consultation.
A number of risk managementThe management of risks which have been identified by risk assessment. It includes the planning, implementation and evaluation of any resulting actions taken to protect consumers, animals and the environment measures to combat AMR are in place related to the food chain. EU legislation on foodborne zoonotic diseases - animal diseases or infections transmissibleCapable of being passed between individuals in the same species, as well as between different species (e.g. from animals to humans) between animals and humans - obliges Member States to monitor trends in AMR in zoonoses and other agents that may present a threat to public health.
At international level, countries cooperate through an Intergovernmental Task Force on AMR which reports to the Codex Alimentarius Commission. The EU and United States have also created a transatlantic task force on AMR issues.